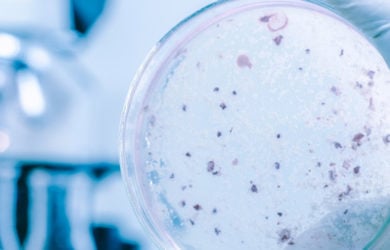

Η νόσος των λεγεωναρίων και τα μέτρα προστασίας
30/07/2019
0
Η νόσος των λεγεωναρίων και τα μέτρα προστασίας Η νόσος των λεγεωναρίων ή λεγεωνέλλωση, έχει ως αιτιολογικό παράγοντα το βακτηρίδιο LEGIONELLA PNEUMOPHILA, που είναι το πιο συνηθισμένο αλλά και επικίνδυνο είδος της οικογένειας LEGIONELLA Τι …